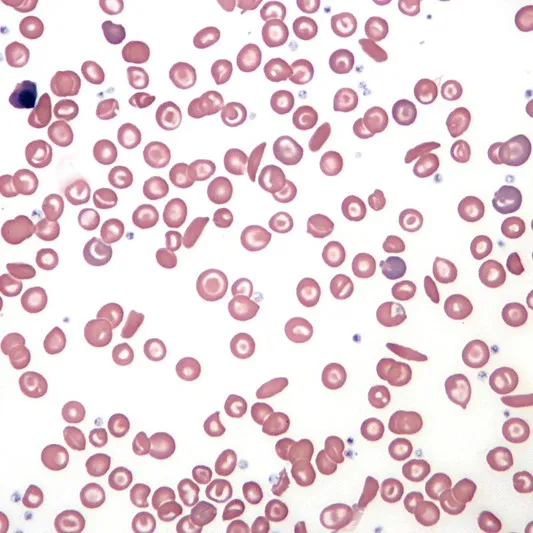

Content Writing
We offer a range of content writing solutions - from corporate communications to feature articles.
Let's work together
If, like us, you are looking for creative ways to root your business in these challenging times, we look forward to working with you.